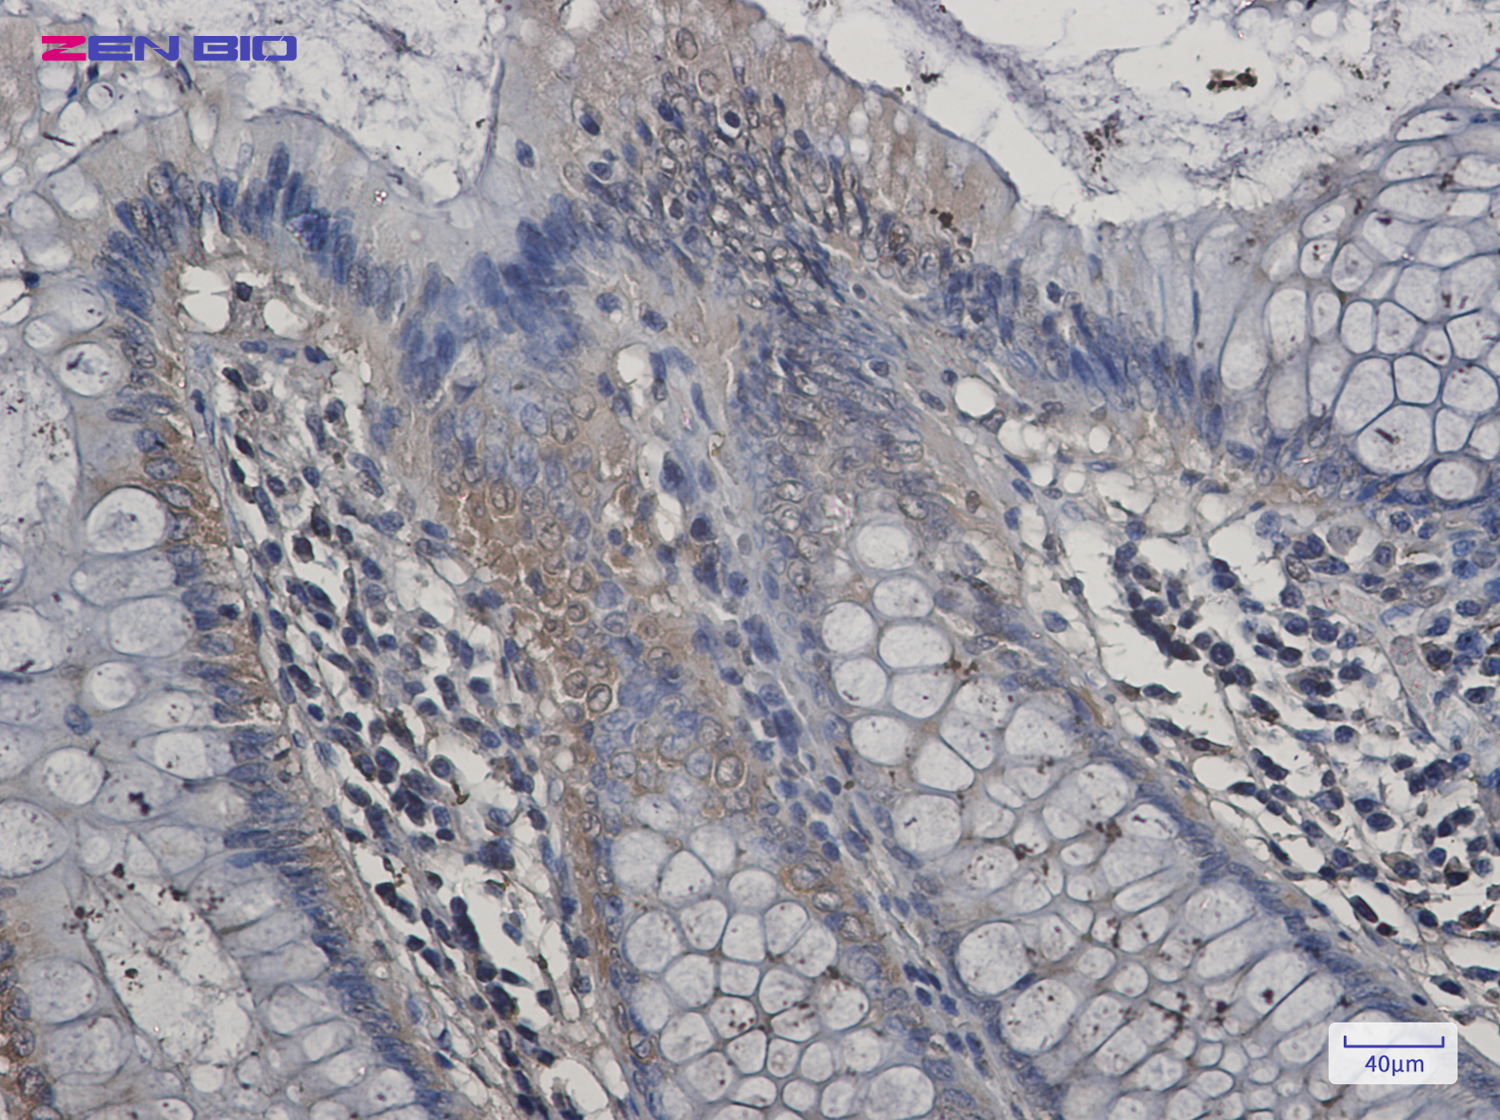

-
Product Name
Anti-Aspartate Aminotransferase Rabbit antibody
- Documents
-
Description
Aspartate Aminotransferase Rabbit polyclonal antibody
-
Tested applications
WB, IHC-P, ICC/IF, FC
-
Species reactivity
Human, Mouse, Rat
-
Alternative names
AST1; cCAT; GIG18; cAspAT; ASTQTL1 antibody
-
Isotype
Rabbit IgG
-
Preparation
Antigen: A synthetic peptide of human Aspartate Aminotransferase
-
Clonality
Polyclonal
-
Formulation
Supplied in 50nM Tris-Glycine(pH 7.4), 0.15M Nacl, 40%Glycerol, 0.01% sodium azide and 0.05% BSA.
-
Storage instructions
Store at -20°C. Stable for 12 months from date of receipt.
-
Applications
WB: 1/1000
IHC: 1/20-1/100
ICC/IF: 1/100
FC: 1/20-1/100
-
Validations
Immunohistochemistry of Aspartate Aminotransferase in paraffin-embedded Human colon cancer tissue using Aspartate Aminotransferase Rabbit pAb at dilution 1/20

Western blot detection of Aspartate Aminotransferase in K562,Rat Brain,3T3,Hela cell lysates using Aspartate Aminotransferase Rabbit pAb(1:1000 diluted).Predicted band size:46kDa.Observed band size:46kDa.
-
Background
Swiss-Prot Acc.P17174.Biosynthesis of L-glutamate from L-aspartate or L-cysteine. Important regulator of levels of glutamate, the major excitatory neurotransmitter of the vertebrate central nervous system. Acts as a scavenger of glutamate in brain neuroprotection. The aspartate aminotransferase activity is involved in hepatic glucose synthesis during development and in adipocyte glyceroneogenesis. Using L-cysteine as substrate, regulates levels of mercaptopyruvate, an important source of hydrogen sulfide. Mercaptopyruvate is converted into H2S via the action of 3-mercaptopyruvate sulfurtransferase (3MST). Hydrogen sulfide is an important synaptic modulator and neuroprotectant in the brain.
Related Products / Services
Please note: All products are "FOR RESEARCH USE ONLY AND ARE NOT INTENDED FOR DIAGNOSTIC OR THERAPEUTIC USE"
